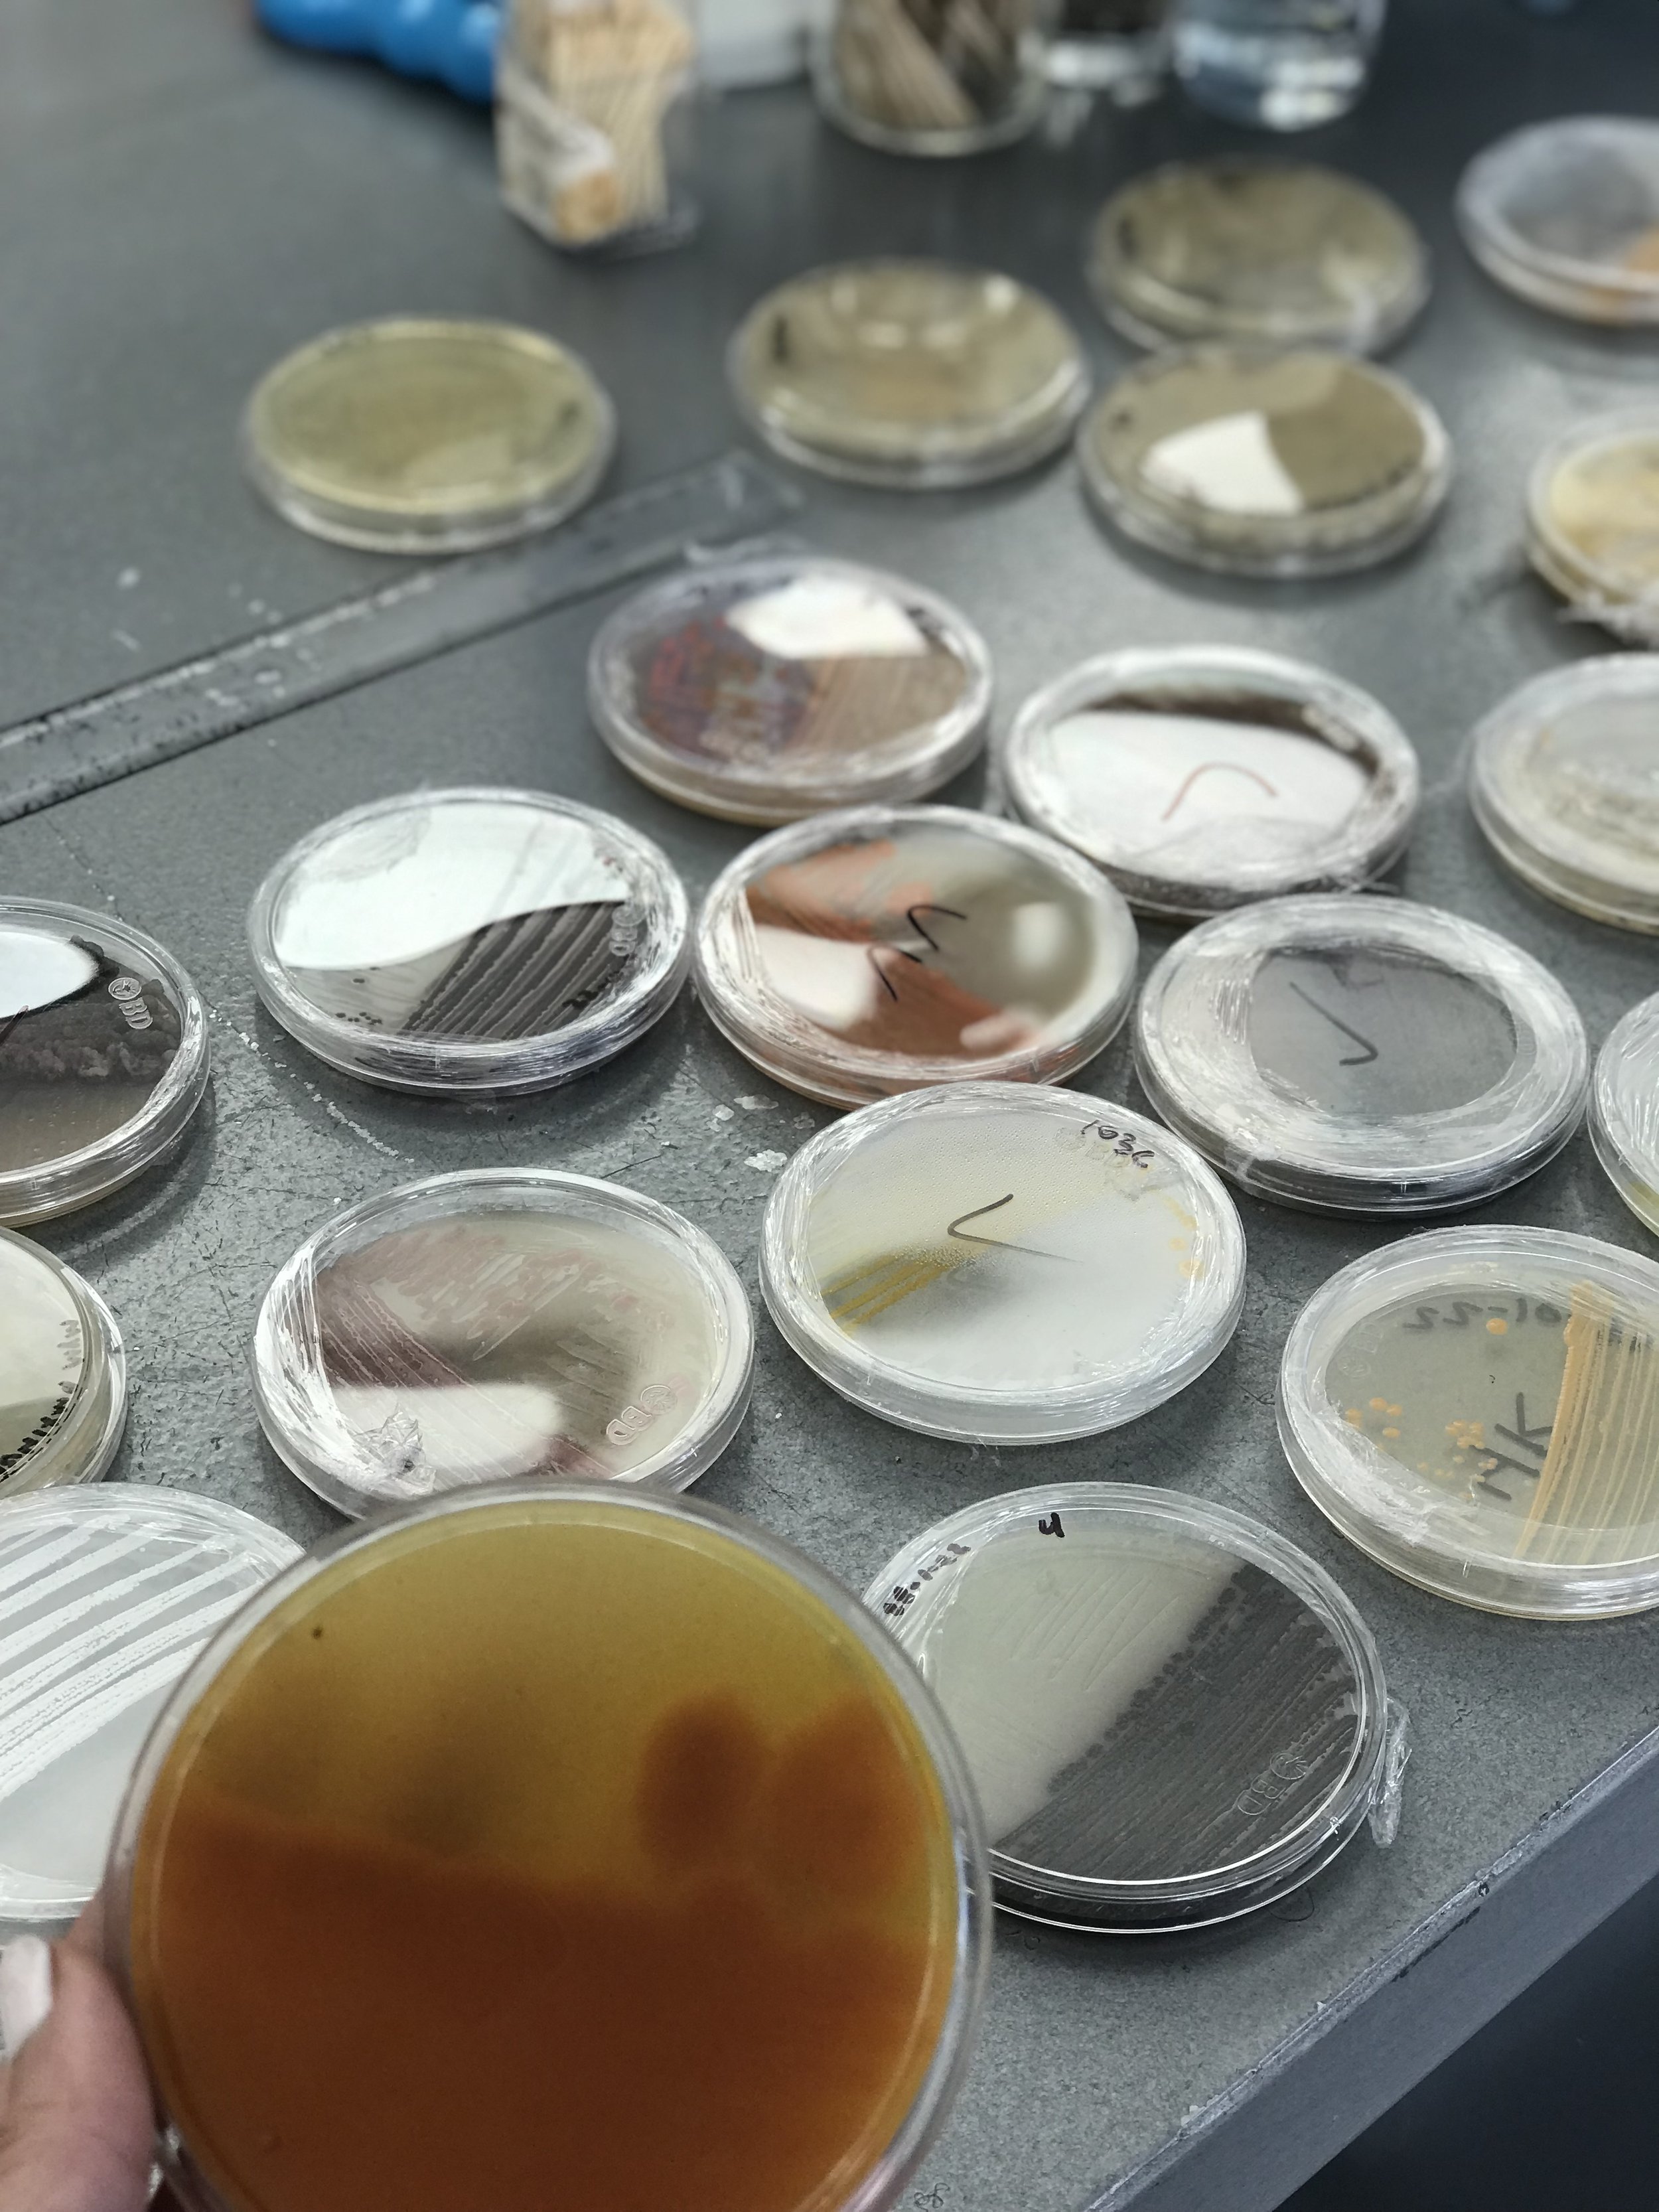
Cuatro-Cienegas-Bacteria.jpeg

Turning Graves into Gardens in a Rare Desert Oasis
“He found him in a desert land, in a place of horror, and of vast wilderness. He led him about, and taught him, and he kept him as the apple of his eye.” (Deuteronomy 32:10)
As we walk through our lenten journey, we might find ourselves in a dark barren desert that can feel unfamiliar and lonely.
Although I’m just coming out of a physical desert experience from my St. Joseph pilgrimage through the Chihuahuan desert of Cuatro Ciénegas, Mexico, I feel myself still very much sitting in that unknown “desert” place in my heart. A familiar feeling I experienced in 2021 after finishing the Consecration to the Virgin Mary.
My friend calls this desert experience “being in the hallway.” She says we’re never actually alone in that hallway. It’s a space of pause and reflection with the One before that next door opens.
Lessons from El Camino de San José
I originally went on this Camino for my second time to pray for growth in my business through St. Joseph’s intercession, our Model of Workmen. But something else kept coming up over and over again for me during those 3 days in the desert. Something I kept pushing to the side after a rough breakup a year ago.
As I sat and listened to our group’s deep reflections on St. Joseph’s legacy, his attractive masculine strength and courage, and his chivalrous spirit, I realized something was pushing me to consider finding my St. Joseph again. As reluctant I was to this idea, some of the conversations I had with fellow pilgrims along the way was clearly the Holy Spirit speaking to me through their stories in an attempt to open my heart to finding a virtuous partner like St. Joseph.
With so many people in our world carrying father, ex-boyfriend, or husband wounds, families falling apart, modern man attempting to redefine what a family is or what being human means, St. Joseph is the patron saint father that our society needs more than ever today. As the Pillar of Families, Dignified Husband of our Mother Mary, Light of Patriarchs, and Earthly Father of our Lord, Jesus Christ, he’s the bearer of light who we can all turn to for guidance as men or with the men in our lives.
I’ve been adamant about not dating over the past year to find comfort within myself and my heart, to work on my own healing, and to reflect on my past relationship. But in my time of reflection and stubbornness, I forgot what it felt like to stay open to His will.
When we’re walking through a fruitless barren land devoid of water- our own desert of sorrows or loneliness- I like to remind myself how impatient or mistrusting we can be as humans when it comes to the greater plan those difficult moments are designed to lead us to.
Holy Desert Experiences
As we walked through the ancient shores of Cuatro Ciénegas, this diverse desert oasis, my mind kept going back to all of the Biblical and Saint references of hardship and revelation in the desert.
The courage and strength it took for the Holy Family to flee into Egypt, an unknown land with no family nor friends, to protect the Bread of Life amid a rough terrain, intense heat, and dangers along the way.
The resistance in St. Anthony the Great, a monk from Egypt who was called into the desert to seek God. He sustained himself on one meal a day of bread and water, yet lived a healthy 105 years of life. Chose a life of extreme isolation and poverty with no education, yet was followed by crowds of people for his wisdom. It fascinates me that even through all of this trials of evil testing him in the desert with the lure of wealth or the fear of demons, he was actually strengthened through his faith, prayer, and fasting.
The hardship and confusion the people of Israel endured in the desert. In the first books of the Old Testament, God keeps the people of Israel in the desert for 40 years. Tired, weak, and untrusting, they decide appoint their own leader to return to Egypt. This rebellion against God and Moses reveals how short-sighted and ungrateful we can be as humans. From the beginning of time we’ve been impatient with God’s timing but remembering to rest in these uneasy and uncomfortable experiences can help us grow into the person He wants us to be.
Even Jesus’ experience in the desert gives us a glimpse into how we too can grow and find strength in a time of temptation and loneliness. Jesus himself was led into the desert for prayer and fasting where he was tempted by Satan for 40 days. Although He was tired and hungry, He was able to withstand His strength in God through each temptation, revealing that even in His fallen state of being human, He is the Son of God, the King of the Universe and, ultimately, overcame what Adam and Eve could not.
the desert lab studying the beginnings of life on Earth
In a desert so rare and diverse offering enlightenment into our inner blooming gardens, it’d be wrong if I didn’t share how unique this place actually is!
During the pilgrimage we learned about Genesis 4C, a microbiology living lab part of the Plan 2040 program of Cuatro Ciénegas. Genesis 4C functions as a union between the scientific community, businesses, and locals, promoting research, science, environmental education, and biotechnological development of the Cuatro Ciénegas Biosphere Reserve.
Director and Biotechnology Scientist at Genesis 4C, Dr. Héctor Arocha, shared how this place is a little gem and slice of Heaven on Earth linked to the beginnings of life, classified by RAMSAR as an essential wetland ecosystem and studied by NASA as one of the most similar places on Earth to Mars.
The Cuatro Ciénegas wetlands are made up of more than 400 turquoise colored streams and ponds, or pozas holding some of the oldest water on the planet with characteristics from the Precambrian Era. It’s also home to 77 endemic species, extremely rare gypsum deposits in the form of sand dunes, and the earliest fossil evidence of life on earth called stromatolites. These microbial reefs emerged in the ocean, formed protective calcium barriers, floated to the surface, and then invented photosynthesis 3.5 billion years ago allowing for life on Earth to form as we know it today.
Cuatro Ciénegas can be seen as an ancient time machine of divine providence, full of living organisms that survived all mass extinctions and paved the way for our blue planet to form and evolve. It’s a place that unites spirituality and reason to understand our evolutionary processes of life on Earth. Resilient and thriving, it’s also a place that’s seen desolate graves of dried up pozas from human destruction turn into living aquatic gardens teeming with thousands of archaic bacteria awaiting to be discovered and giving us a peek into what early life on Earth may have looked like.
“Our work here is key in helping others understand the importance of protecting our natural environment and our place in it. If the locals don’t understand the fragility of this place and the importance of protecting it, then we aren’t protecting our own people. I like to say, conocer para conservar. Understand to then protect.”
My reflections from all of these desert trials, experiences, and the incredible work being done at Genesis 4C, is that He wants us to thirst for him and to see that our struggles and sufferings can never bury us because of His grace. That freedom lies within His fruits turning our graves into gardens because through Him, every failure becomes a victory, every pain a fortitude, and injustice a justice.
For me, going into a place of spiritual solitude around a beautiful landscape of natural abundance like the desert biosphere of Cuatro Ciénegas, helps me clear my mind of the distractions and the weight of the world. It gives me hope because I know that His love releases the pains and struggles that feel too heavy to carry, and also because I know that with a little effort, He’ll eventually lead me to my St. Joseph. 😉
St. Joseph Prayer of St. Francis de Sales
Glorious St Joseph, spouse of Mary, grant us thy paternal protection, we beseech thee by the heart of Jesus Christ. O thou, whose power extends to all our necessities and can render possible for us the most impossible things, open thy fatherly eyes to the needs of thy children.
In the trouble and distress which afflicts us, we confidently have recourse to thee. Deign to take under your charitable charge this important and difficult matter, cause of our worries. Make its happy outcome be for God's glory and for the good of His devoted servants. Amen.
Related Stories